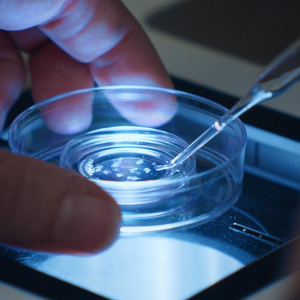

"Festival ImagéSanté", au "Sauvenière", à Liège : 2 avant-Premières, les 10 & 19 Juin

Le « Festival ImageéSanté » nous invite au « Cinéma Sauvenière », à Liège, pour assister à deux avant-premières, suivies, chacune, d’une rencontre-débat :
*** « Monstres de Poussière » (Nina Marissiaux/Belgique/documentaire/2024/74’/film présenté en compétition, en mars 2025, lors du 16è « Festival international du film Millenium »), le mardi 10 juin, 20h. Tarif préférentiel : 8€.
Synopsis : « Comment rester en vie quand tout semble nous pousser à mourir ? D’anciens sans-abris nous racontent la difficulté de réintégrer la société avec les blessures béantes que la rue leur a laissées. Le film révèle la violence et l’incompréhension de tout un système à l’égard de ces invisibles … »
La réalisatrice Nina Marissiaux, nous confie : « Johnny et Goyko ont été sans-abris et tentent de se raconter dans un film. Le chemin n’est pas simple pour retrouver la simple légitimité de partager son histoire. Ensemble, nous nous questionnons sur les liens si particuliers que crée le cinéma documentaire … Ce film est une rencontre et une réflexion sur ce que les liens créés par le cinéma documentaire impliquent, comment ils se construisent, à quoi ils servent et ce qu’ils deviennent quand le film se termine. »
Nina Marissiaux (°Liège/1996), une réalisatrice locale, qui étudia le cinéma à la « Haute Ecole libre », à Bruxelles, où elle réalisa son premier court métrage documentaire “Suspension d’Audience” (Belgique/documentaire/2018/ 24′), récompensé à plusieurs reprises, notamment, en 2018, par le « Prix national du Jury officiel » de la 6è édition du « Festival Les Enfants terribles », à Huy.
La projection sera suivie d’une rencontre-débat avec la réalisatrice et des protagonistes de ce documentaire, ainsi qu’avec Francine Ravyts-Lenz de l’asbl « Les Sentinelles de la Nuit ».
*** « Le Rêve des Cigognes » (Élodie Lélu/Belgique/documentaire/2024/62′). Tarif préférentiel : 8€.
Synopsis : « En partant de son vécu, qu’elle prolonge par les témoignages d’autres personnes infertiles, la réalisatrice, Élodie Lélu, montre comment la procréation médicalement assistée modifie le rapport au corps et à l’imaginaire. À travers un cœur de voix féminines et masculines, ce documentaire au ton espiègle questionne les représentations autour de la fécondation in vitro, en mêlant archives familiales, images scientifiques et tout un registre d’images intrigantes, qui viennent remettre du rêve là où la science donne tout (trop ?) à voir … »
Élodie Lélu (1982-2024), trop tôt disparue, fut une réalisatrice belgo-française, née en Bretagne, qui, après des études en « Histoire de l’Art », étudia, à Bruxelles, à l’ « INSAS » (« INstitut Supérieur des Arts du Spectacle »), avant de se perfectionner en cinéma, aux côtés du réalisateur grec Théo Angelopoulos (1935-2012).
La projection sera suivie d’une rencontre-débat avec l’assistante à la réalisation d’Elodie Lélu, Marion Minery, la productrice, Isabelle Truc, productrice, & Marine Manard, la psychologue pour le magazine liégeois « Parentalité sans Tabou », la modération étant assurée par Pierre Duculot, secrétaire général de « Wallonie Image ».
Le « Festival ImageéSanté » étant une biennale, la 17è édition se déroulera en 2027. Un appel des organisateurs est, d’ores et déjà, lancé aux personnes intéressées de rejoindre les comités de visionnage. Pour pouvoir participer, entre mai & octobre 2026, à ces visionnages d’environ 350 films documentaires, il vous suffit d’envoyer un courriel à info@imagesante.be, en précisant votre profil & vos motivations. Sites web : https://www.imagesante.be/ & https://grignoux.be/.
Yves Calbert.